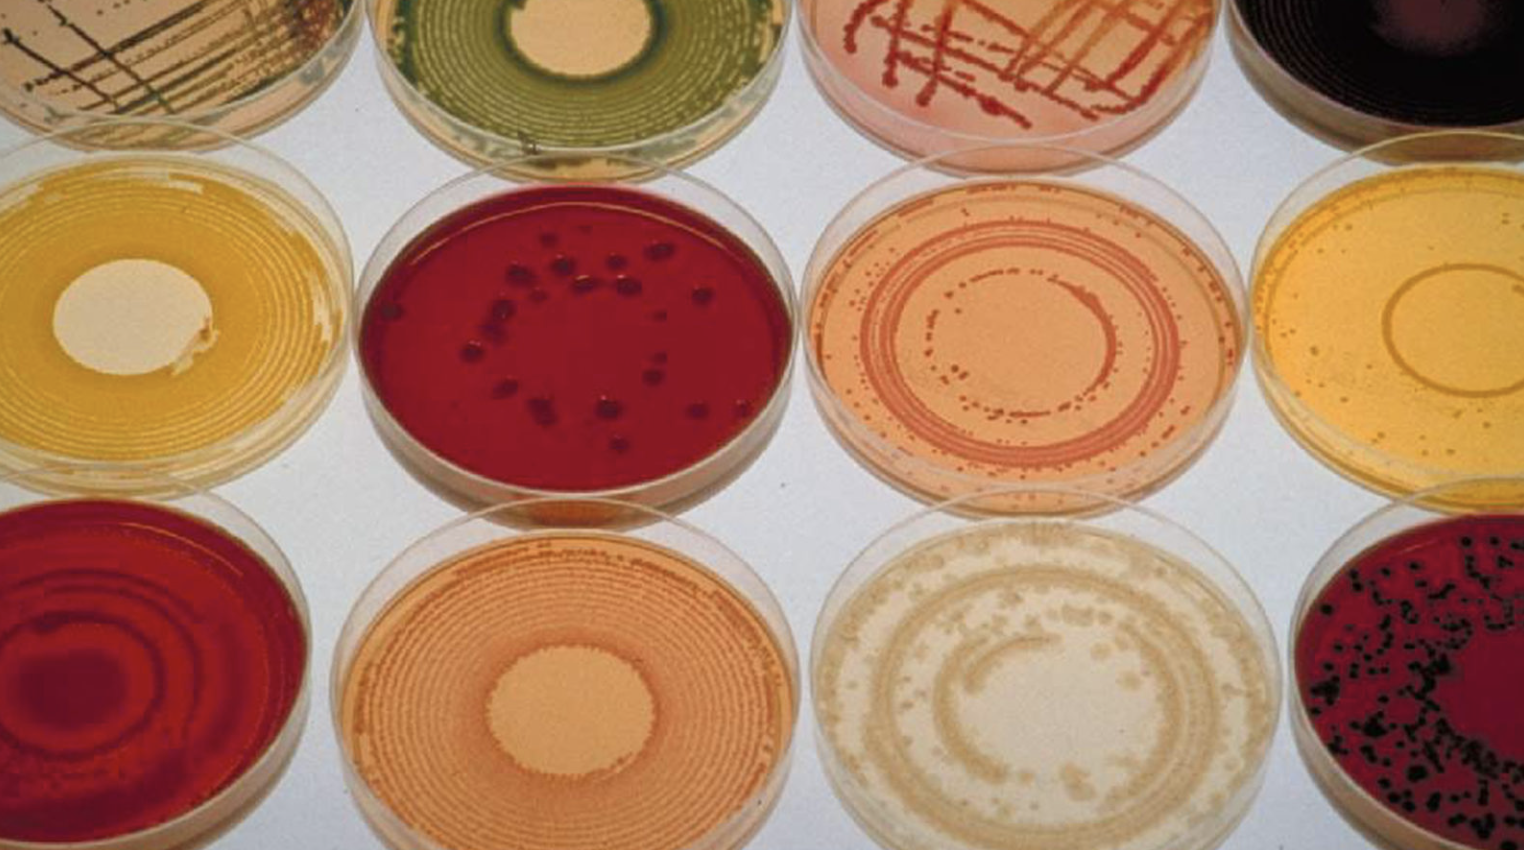

Understanding the Gut Microbiome & How to Support It
‘The Gut’ and ‘The Microbiome’ are talked about more and more but do you actually know what these terms are referring to? They’re topical subjects for good reason - the impact that the gut/microbiome has on our health is widespread and significant. Let me unpack these terms for you and bring light to the big role they play in the way you feel, think and behave.
‘The Gut’ really refers to any of the happenings from the mouth all the way through to the anus. This is technically ‘the outside world’ as it’s a tube all the way through our body and acts as an important barrier between the outside world and our insides. It also includes the digestion and absorption capabilities of the gastrointestinal tract.
When bacteria are talked about in relation to health they are often referring to infections that drive sickness. While this is true we also have 10-100 trillion beneficial microbes (a combination of bacteria, viruses and fungi) residing within our ‘gut’. Majority of these live in our large intestine while there are less in the small intestine and stomach. The genetic material that makes up these microbes is what the ‘microbiome’ is referring to. While the ‘microbiota’ is the official term for the microbes themselve.
I like to think of the microbiota as a beneficial forest - it should be a diverse and thriving ecosystem. The more growth and diversity there is the less likely ‘weeds’ or unfriendly microbes will be able to grow.
It’s the balance of these microbes that impacts our health. When the so-called ‘forest’ is more so a barren desert or laced with weeds the ecosystem fails and the body feels the effects of this. Some researchers believe that up to 90% of illness can be traced back to the gut.
The biggest areas I see clinically that are impacted by gut health are:
Mental Health
Immunity and autoimmunity
Inflammatory conditions
Energy levels
Brain fog
And of course any symptom directly related to the gut e.g. bowel motions, reflux, bloating and gut pain.
There are 3 key areas to think about when fostering a healthy gut.
Digestion
Intestinal lining
Microbiome
Digestion
When we look at digestion from a top down approach each different phase of digestion is reliant on the previous phase working adequately. The below list details what you can do to support each phase in the order that they occur internally:
Brain:
Yes, digestion begins in the brain! Looking, smelling and feeling foods begins what we call the cephalic phase of digestion. This turns on the digestive tract and begins the production of digestive enzymes:
Majority of the time:
Spend time preparing your food and being present with it (not just receiving it pre prepared as a takeaway)
Don’t eat your food in a hurry. Take your time as you eat - eating while stressed will cause your brain to turn off your gut.
Mouth:
We have teeth for a reason! This is a huge part of digestion. We don’t have teeth anywhere else in our digestive tract and the downstream areas are reliant on our food being well chewed.
Chew your food until it’s a mush/liquid.
Stomach:
Our stomach is VERY acidic in order to break down food, particularly proteins. It has a pH of 1.5 - 3.5. In many cases when people experience reflux or poor digestion it’s because they don’t have enough acid prodction.
Take 1Tb of apple cider vinegar in a glass of water before eating
Chew your food properly to help stimulate acid production
Take a zinc supplement
Small Intestine:
This is where we produce digestive enzymes to really break foods down to the smallest molecules. This is also where those molecules are absorbed across the intestinal wall.
Avoid eating foods that are difficult to digest e.g. processed foods! ‘Foods’ containing things such as emulsifiers, flavours, thickeners etc can aggravate the small intestine and disrupt digestion.
Hydrate well to help sweep food through the small intestine. 2-3L per day.
Give yourself 3-4 hours between meals or snacks to avoid overwhelming your small intestine.
2. Intestinal Lining
The intestinal lining is such an important immune barrier between us and the outside world. To find out more about this area of your gut and what you can do to support it read here.
3. Microbiome
The microbiome largely lives in the large intestine where waste elimination occurs. I like to think of this part of the digestive tract as like the ‘compost’ bin. All the leftover food (largley just fibre by this point) is put here and with the help of a healthy array of microbes gets turned into something really beneficial! This being a good bowel motion but also the many roles that the microbes play in our health - communication to other areas of our body and the many compounds that are produced by bacteria e.g. neurotransmitters, anti-inflammatory molecules and nutrients.
Eat plenty of fibre to feed the beneficial bacteria and help to sweep the large bowel out. Aim for 30g per day which you will get in if you aim for the majority of your diet coming from plants - fruit, vegetables, greens, legumes, nuts, seeds, grains.
Include as much diversity in your diet as possible - the different colours and fibres in different produce feed different bacteria - the more diverse your diet is the more diverse our microbiome will be.
Hydrate well - 2-3L per day.
Eat prebiotic foods which feed the beneficial microbes - apples, mushrooms, leeks, onions, garlic, artichokes, asparagus, oats, barley, cocoa, avocado, bananas, seaweed to name a few.
Eat probiotic foods which contain beneficial bacteria - sauerkraut, kimchi, yoghurt, miso, apple cider vinegar, kombucha, kefir, kvass to name a few.
Move your body daily. This doesn’t need to be excessive amounts of exercise, just aiming for 7000 - 10,000 steps per day is a great goal.
Save alcohol for the weekends and special occasions. Alcohol damages our mirobiome and results in less growth and less diversity.
Avoid sugar which feeds unfriendly microbes in the gut.
Avoid ultra processed and packaged foods which prevent good microbial growth and encourage the growth of unfriendly microbes.
Minimise stress
Prioritise 8 hours of sleep per night
It can feel like a lot to do but if you note down 1-3 things that are achievable and commit to these for the next month you’ll be one step ahead! Once those things become habitual, move onto aonther 1-3 things.
Please sing out with any questions in the comments below.
Grace x